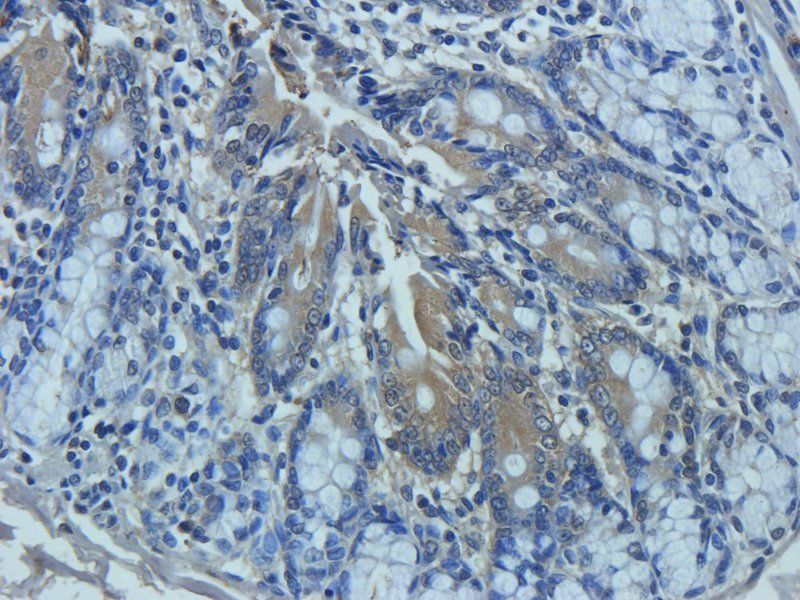
Mucin 5AC antibody
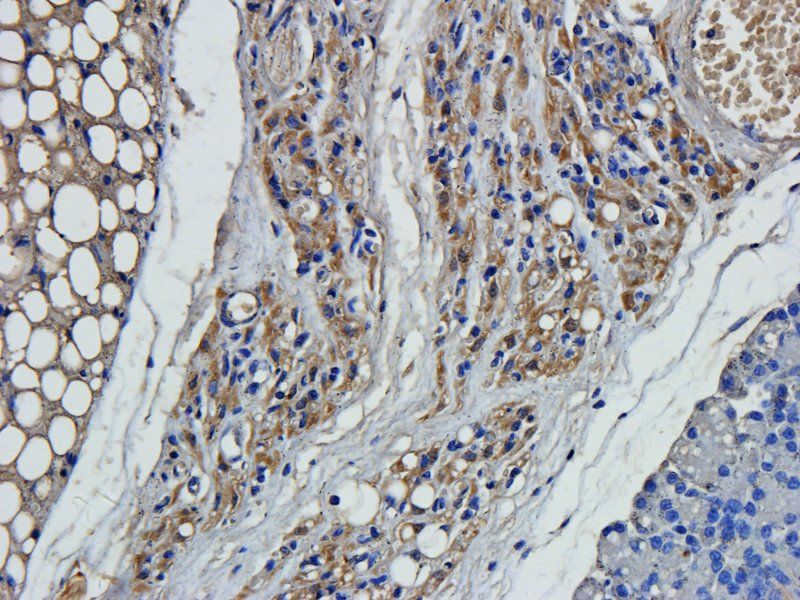
ZNT8 antibody

You have no items in your shopping cart.
All Products
- Desmocollin 1 antibody [orb101537]Featured

ELISA, ICC, IF, IHC-P, WB
Human, Mouse, Rat
Rabbit
Polyclonal
Unconjugated
100 μg - VEGFR3 antibody [orb315557]Featured

ELISA, IHC-P, WB
Human, Mouse, Rat
Rabbit
Polyclonal
Unconjugated
100 μg - Cathepsin G antibody [orb322976]Featured

ELISA, IHC-P, WB
Human, Mouse, Rat
Rabbit
Polyclonal
Unconjugated
100 μg - ZNT8 antibody [orb158829]Featured

ELISA, IHC-P, WB
Human, Mouse, Rat
Rabbit
Polyclonal
Unconjugated
100 μg - Tubulin beta 3 antibody [orb378207]Featured

ICC, IF, IHC-P, WB
Human, Mouse, Rat
Rabbit
Polyclonal
Unconjugated
100 μg - CD81 antibody [orb378210]
ICC, IF, IHC-P, WB
Human, Mouse, Porcine, Rat
Rabbit
Polyclonal
Unconjugated
100 μg - CXCL11 antibody [orb191499]Featured

ELISA, ICC, IF, IHC-P, WB
Mouse, Porcine, Rat
Rabbit
Polyclonal
Unconjugated
100 μg